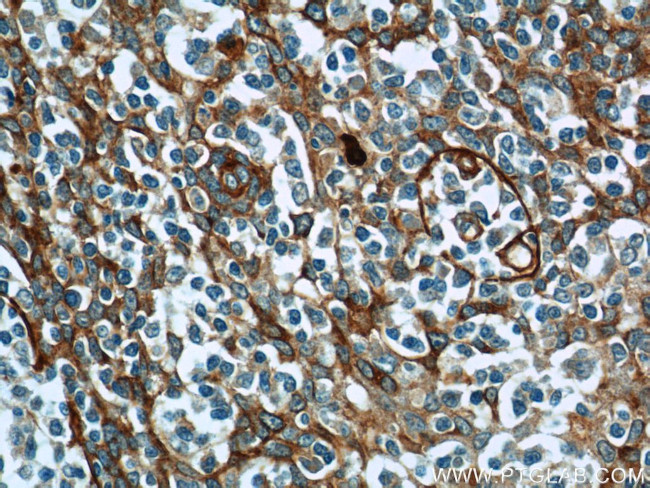
ADAM8 Antibody in Immunohistochemistry (Paraffin) (IHC (P))

Search
Proteintech
ADAM8 Polyclonal Antibody
{{$productOrderCtrl.translations['antibody.pdp.commerceCard.promotion.promotions']}}
{{$productOrderCtrl.translations['antibody.pdp.commerceCard.promotion.viewpromo']}}
{{$productOrderCtrl.translations['antibody.pdp.commerceCard.promotion.promocode']}}: {{promo.promoCode}} {{promo.promoTitle}} {{promo.promoDescription}}. {{$productOrderCtrl.translations['antibody.pdp.commerceCard.promotion.learnmore']}}
产品信息
23778-1-AP
种属反应
已发表种属
宿主/亚型
分类
类型
抗原
偶联物
形式
浓度
规格
纯化类型
保存液
内含物
保存条件
运输条件
产品详细信息
This antibody is specific to ADAM8.
Immunogen sequence: EGGEGGRHA VYQAEHLLQT AGTCGVSDDS LGSLLGPRTA AVFRPRPGDS LPSRETRYVE LYVVVDNAEF QMLGSEAAVR HRVLEVVNHV DKLYQKLNFR VVLVGLEIWN SQDRFHVSPD PSVTLENLLT WQARQRTRRH LHDNVQLITG VDFTGTTVGF ARVSAMCSHS SGAVNQDHSK NPVGVACTMA HEMGHNLGMD HDENVQGCRC QERFEAGRCI MAGSIGSSFP RMFSDCSQAY LESFLERPQS VCLANAPDLS HLVGGPVCGN LFVERGEQCD CGPPEDCRNR CCNSTTCQLA EGAQCAHGTC CQECKVKPAG ELCRPKKDMC DLEEFCDGRH PECPEDAFQE N (145-494 aa encoded by BC115404)
靶标信息
This gene encodes a member of the ADAM (a disintegrin and metalloprotease domain) family. Members of this family are membrane-anchored proteins structurally related to snake venom disintegrins, and have been implicated in a variety of biological processes involving cell-cell and cell-matrix interactions, including fertilization, muscle development, and neurogenesis. The protein encoded by this gene may be involved in cell adhesion during neurodegeneration, and it is thought to be a target for allergic respiratory diseases, including asthma. Alternative splicing results in multiple transcript variants.
仅用于科研。不用于诊断过程。未经明确授权不得转售。
生物信息学
蛋白别名: a disintegrin and metalloproteinase; a disintegrin and metalloproteinase domain 8; ADAM; ADAM 8; ADAMs; CD156a; Cell surface antigen MS2; Disintegrin and metalloproteinase domain-containing protein 8; human leukocyte differentiation antigen; Macrophage cysteine-rich glycoprotein; metalloendopeptidases; MGC134985; unnamed protein product
基因别名: ADAM 8; ADAM8; CD156; CD156a; E430039A18Rik; MS2
UniProt ID: (Human) P78325, (Mouse) Q05910
Entrez Gene ID: (Human) 101, (Mouse) 11501